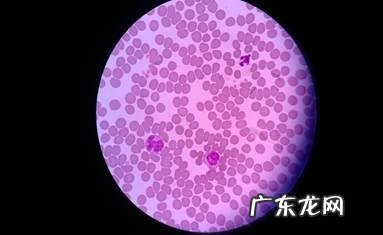
一例蜱虫叮咬的病例分析

文章插图
金毛(详细介绍)
下边是一例蜱虫叮咬小狗的病例分析 , 蜱虫在春天较为普遍 , 主人家要在这段时间留意小狗出门时 , 不必被蜱虫叮咬到 。
一、病畜基本资料
种类:中华田园犬
年纪:1y
性別:♂(未去势)
休重:5kg
【一例蜱虫叮咬的病例分析】就医缘故:主人家在宠物狗狗右边嘴巴发觉一已经饮血的蜱虫 , 在家里将其自主拔掉;
二、临床医学查验
1.基础查验
人体体温:38℃
心跳:168次/分
吸气:28次/分
2.血液学查验

文章插图
血常规检查

文章插图
血涂片:末见显著出现异常
文章插图
血涂片:末见显著出现异常
3.爱德士犬四合一测纸检测(呈阴性)

文章插图

文章插图
4.人体别的地区未出现异常
三、医治及常见问题
1、祛除及防止蜱虫叮咬;
2、提升饮食搭配 , 适度喂养补气血营养保健品;
3、紧密观查萌宠个人行为情况是否出现异常;
四、剖析汇总
1.有关蜱虫:
蜱虫 , 又称为“壁虱”、“狗豆子”;普遍种属:扇头蜱属、硬蜱属、血蜱属等 。在其中猩红扇头蜱是中国最普遍的 , 是一只三寄主蜱虫 , 一生要饮血3次;
如何感柒的蜱虫?蜱虫粘附在绿色植物的叶片或是草尖上 , 一旦小宠物历经 , 就趁机爬到小宠物的身上饮血;普遍的饮血位置:(头发较少、肌肤较薄、血夜丰富多彩、更非常容易触碰叶片和草尖)脸部、耳朵、腋窝下、脚指头间;
怎样饮血:蜱虫饮血时 , 起先开启触须 , 讲口器置入肌肤 , 再是吐入唾沫 , 及很多的细菌和内毒素 , 后刚开始饮血 。母蜱虫饮血后的休重有时候为饮血前的100倍;

文章插图

文章插图
2.蜱虫的伤害:
皮肤发炎;缺铁性贫血;传播疾病:巴贝斯虫病、无形体病、球菌病等;蜱偏瘫等 。
3.如何预防:
由于蜱虫叮咬致人死亡的病案每一年与日俱增 , 谨记在萌宠的身上发觉蜱虫时千万别拿手将其拔掉 , 尽早将萌宠送到靠谱的宠物医院做全方位的检查身体 。
防止因蜱虫的咬后散播的病源和内毒素给萌宠与人产生多余的损害;每个月还记得给萌宠除虫及防止身体外裂头蚴 , 防止超过医治!
特别声明:本站内容均来自网友提供或互联网,仅供参考,请勿用于商业和其他非法用途。如果侵犯了您的权益请与我们联系,我们将在24小时内删除。
